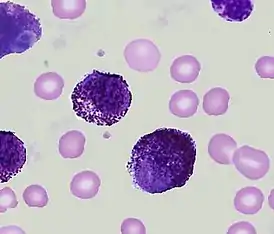

Острый тучноклеточный лейкоз
Острый тучноклеточный лейкоз — это очень редкая, но исключительно агрессивная форма острого миелоидного лейкоза, которая обычно возникает de novo, но может изредка возникать как злокачественная трансформация хронического миелоидного лейкоза в более агрессивный острый миелоидный лейкоз (так называемая «бластная трансформация» и следующий за ней «бластный криз»). В небольшом проценте случаев острый тучноклеточный лейкоз происходит от более быстро прогрессирующей формы системного мастоцитоза. Диагноз острого тучноклеточного лейкоза согласно критериям ВОЗ требует наличия не менее чем 20 % злокачественных тучных клеток в костном мозге и не менее чем 10 % от общего количества «белых клеток» в крови.[1] Если злокачественные тучные клетки составляют менее чем 10 % всех обладающих ядрами (то есть «белых») клеток крови, то эта форма называется «алейкемическим» или «сублейкемическим» острым тучноклеточным лейкозом.
| Острый тучноклеточный лейкоз | |
|---|---|
Мазок периферической крови больного острым тучноклеточным лейкозом | |
| МКБ-11 | 2A21.00 |
| МКБ-10 | C94.3 |
| МКБ-10-КМ | C94.30 и C94.3 |
| МКБ-9 | 207.8 |
| МКБ-О | M9742/3 |
| DiseasesDB | 30102 |
| MeSH | D007946 |
Лабораторные находки
Цитохимия
Цитохимические свойства лейкозных клеток для диагноза «острый тучноклеточный лейкоз» должны соответствовать и быть типичными для тучных клеток (присутствие метахроматическиъ гранул, положительно окрашиваемых на альфа-нафтил-хлороацетат-эстеразу, но не на пероксидазу).[2] Тучноклеточная триптаза является ферментом, который содержится в гранулах тучных клеток. Количество тучных клеток легче всего подсчитать при помощи иммуногистохимической окраски на триптазу, поскольку плохо гранулированные злокачественные тучные клетки могут плохо, очень плохо или совсем не окрашиваться положительно на альфа-нафтил-хлороацетат-эстеразу.[1]
Опухолевые маркеры
Лейкозные тучные клетки обычно резко положительны на поверхностные антигены CD13, CD33, CD68 и CD117. Базофильные (например CD11b, CD123) и моноцитарные (например CD14, CD15) маркеры отсутствуют. Клетки обычно экспрессируют CD2 и CD25.[3] Злокачественные тучные клетки гиперэкспрессируют антиапоптотический белок Bcl-2.[4] У большинства пациентов наблюдается мутация в гене KIT.[5]
Биохимия
Общее содержание триптазы в сыворотке крови при остром тучноклеточном лейкозе повышено. Нормальный уровень общей (альфа + бета изоформы) сывороточной триптазы в среднем около 6 мкг/л (диапазон от 0 до 11 мкг/л). Уровни порядка сотен мкг/л характерны для острого тучноклеточного лейкоза.[6] Уровни гистамина в плазме крови и в моче часто бывают повышены у больных с острым тучноклеточным лейкозом. Фермент гистидин-декарбоксилаза — это фермент, который катализирует реакцию превращения гистидина в гистамин. Измерение уровня гистидин-декарбоксилазы в клетках костного мозга пациентов является очень чувствительным маркером наличия и количества тучных клеток в костном мозге.[7]
Клиническое течение
Острый тучноклеточный лейкоз имеет агрессивное, быстро прогрессирующее течение с большим количеством лейкозных тучных клеток в костном мозге и в крови. Типичные симптомы включают лихорадку, головные боли, приливы жара к лицу и шее с их покраснением (в связи с выделением гистамина).[8][9] Типичные кожные тучноклеточные инфильтраты пигментной крапивницы у больных с острым тучноклеточным лейкозом отсутствуют как до, так и на момент постановки диагноза, и после.[10] Симптомы нередко включают в себя боль в животе, боли в костях, пептическую язву желудка, которая встречается гораздо чаще, чем при других подтипах ОМЛ. Эти симптомы также связаны с выделением опухолевыми клетками большого количества гистамина.[11] Увеличение размеров печени и селезёнки, или, иначе говоря, гепатомегалия и спленомегалия также весьма характерны.[2] Злокачественные тучные клетки также выделяют большое количество различных антикоагулянтов, таких, как гепарин, что, вкупе с тромбоцитопенией, может привести к серьёзным кровотечениям. Нарушение функции печени и селезёнки также способствуют кровотечениям.[12] Вовлечение костей в опухолевый процесс, а также вымывание кальция из них под влиянием гепарина и других выделяемых тучными клетками биологически активных веществ часто приводит к развитию у этих больных остеопороза. Для диагностики важно ультразвуковое исследование органов брюшной полости и компьютерная томография тела, позволяющие выявить не характерную для многих других типов ОМЛ выраженную гепатомегалию, спленомегалию и лимфаденопатию. Для оценки наличия остеопороза необходима радиография костей и денситометрия. Показана верхняя и нижняя эндоскопия и биопсия в связи с частым вовлечением в опухолевый процесс желудка и кишечника и частым наличием в желудке пептических язв.[13]
Лечение
Иммуноглобулин E (IgE) важен для функционирования тучных клеток. Экспериментальная иммунотерапия анти-IgE иммуноглобулином привела к кратковременному снижению количества циркулирующих бластных тучных клеток у одного больного с острым тучноклеточным лейкозом.[14] Хотя спленэктомия приводит к кратковременному улучшению состояния больных с острым тучноклеточным лейкозом и кратковременному уменьшению количества циркулирующих бластных тучных клеток, нет возможности сделать твёрдое заключение об эффективности или показанности такого лечения, ввиду малого числа пациентов и наблюдений.[10][15]. Химиотерапия по протоколам, предназначенным для лечения других форм ОМЛ (например, 7+3 с цитарабином и даунорубицином, или идарубицином, или митоксантроном, или ADE с добавлением также этопозида, или FLAG-подобные режимы) может помочь, однако её эффективность при данной форме ОМЛ детально не исследовалась. Трансплантация гемопоэтических стволовых клеток — возможная опция, но пока нет данных касательно ответа на эту терапию и отдалённых результатов лечения (с точки зрения общей и безрецидивной выживаемости).[5]
Прогноз
Острый тучноклеточный лейкоз является исключительно агрессивной формой острого миелоидного лейкоза и имеет очень плохой прогноз. В подавляющем большинстве случаев мультиорганная недостаточность, включая костномозговую недостаточность, развивается в течение нескольких недель или месяцев с момента установления диагноза.[16] Медиана выживаемости после установления диагноза — всего около 6 месяцев.[10]
Примечания
- Lichtman M.A., Segel G.B. Uncommon phenotypes of acute myelogenous leukemia: basophilic, mast cell, eosinophilic, and myeloid dendritic cell subtypes: a review (англ.) // Blood Cells, Molecules and Diseases : journal. — 2005. — Vol. 35, no. 3. — P. 370—383. — doi:10.1016/j.bcmd.2005.08.006. — PMID 16203163.
- Kufe D., et al. Holland Frei Cancer Medicine (неопр.). — 5th. — BC Decker, 2000.
- Valent P. 1995 Mack-Forster Award Lecture. Review. Mast cell differentiation antigens: expression in normal and malignant cells and use for diagnostic purposes (англ.) // European Journal of Clinical Investigation : journal. — 1995. — October (vol. 25, no. 10). — P. 715—720. — doi:10.1111/j.1365-2362.1995.tb01948.x. — PMID 8557056.
- Cerveró C., Escribano L., San Miguel J.F., et al. Expression of Bcl-2 by human bone marrow mast cells and its overexpression in mast cell leukemia (англ.) // American Journal of Hematology : journal. — 1999. — March (vol. 60, no. 3). — P. 191—195. — doi:10.1002/(SICI)1096-8652(199903)60:3<191::AID-AJH4>3.0.CO;2-Y. — PMID 10072109.
- Rare Hematological Malignancies (неопр.) / Ansell S. M.. — Springer, 2008. — (Cancer Treatment & Research).
- Sperr W.R., Jordan J.H., Fiegl M., et al. Serum tryptase levels in patients with mastocytosis: correlation with mast cell burden and implication for defining the category of disease (англ.) // Int. Arch. Allergy Immunol. : journal. — 2002. — June (vol. 128, no. 2). — P. 136—141. — doi:10.1159/000059404. — PMID 12065914.
- Krauth M.T., Agis H., Aichberger K.J., et al. Abstracts of the American Society of Hematology 46th Annual Meeting. December 4-7, 2004, San Diego, California, USA (англ.) // Blood : journal. — American Society of Hematology, 2004. — November (vol. 104, no. 11 Pt 2). — P. 272b. — PMID 15562525.
- Daniel M.T., Flandrin G., Bernard J. [Acute mast-cell leukemia. Cytochemical and ultrastructural study, about a particular case (author's transl)] (фр.) // Nouv Rev Fr Hematol. — 1975. — Т. 15, № 3. — С. 319—332. — PMID 54900.
- Le Cam M.T., Wolkenstein P., Cosnes A., et al. [Acute mast cell leukemia disclosed by vasomotor flushing] (фр.) // Ann Dermatol Venereol. — 1997. — Т. 124, № 9. — С. 621—622. — PMID 9739925.
- Travis W.D., Li C.Y., Hoagland H.C., Travis L.B., Banks P.M. Mast cell leukemia: report of a case and review of the literature (англ.) // Mayo Clinic Proceedings : journal. — 1986. — December (vol. 61, no. 12). — P. 957—966. — doi:10.1016/s0025-6196(12)62636-6. — PMID 3095598.
- Valent P., Sperr W.R., Samorapoompichit P., et al. Myelomastocytic overlap syndromes: biology, criteria, and relationship to mastocytosis (англ.) // Leukemia Research : journal. — 2001. — July (vol. 25, no. 7). — P. 595—602. — doi:10.1016/S0145-2126(01)00040-6. — PMID 11377685.
- Cather J.C., Menter M.A. Red-brown skin lesions and pruritus (неопр.) // Proc (Bayl Univ Med Cent). — 2000. — July (т. 13, № 3). — С. 297—299. — PMID 16389403.
- Hoffbrand A. V., Catovsky D., Tuddenham E. Postgraduate Haematology (неопр.). — 5th. — Blackwell, 2005.
- Ribeiro I., Carvalho I.R., Fontes M., et al. Eosinophilic leukaemia with trisomy 8 and double gammopathy (англ.) // Journal of Clinical Pathology : journal. — 1993. — July (vol. 46, no. 7). — P. 672—673. — doi:10.1136/jcp.46.7.672. — PMID 8157759.
- Dalton R., Chan L., Batten E., Eridani S. Mast cell leukaemia: evidence for bone marrow origin of the pathological clone (англ.) // British Journal of Haematology : journal. — 1986. — October (vol. 64, no. 2). — P. 397—406. — doi:10.1111/j.1365-2141.1986.tb04133.x. — PMID 3096368.
- Hoffman R., Benz E., Shattil S., Furie B., Cohen H. Hematology: Basic Principles and Practice (англ.). — 4th. — Churchill Livingstone, 2004.